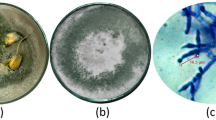

Abstract
IN an interesting letter (NATURE, May 3, 1930, p. 672) Mr. Kirkpatrick states that in the Gezira area (Sudan) an undetermined species of Aleurodidæ causes leaf-crinkle. In the Punjab (N.W. India) Bemisia gossypiperda, Misra and Lamba (Aleurodidæ), has been under observation during the last two years. This insect is present in enormous numbers but is not known to cause any deformation of the attacked leaves. Even in cages under conditions of a pure infestation of B. gossypiperda leaves literally covered on the under side with all the stages of the pest—eggs, nymphs, pupæ, and adults—remain quite flat and normal, and do not show curling, wrinkling, or crinkling. On the other hand, Empoasca devastans (Jassidæ) definitely causes leaf-crinkle.
This is a preview of subscription content, access via your institution
Access options
Subscribe to this journal
Receive 51 print issues and online access
$199.00 per year
only $3.90 per issue
Buy this article
- Purchase on SpringerLink
- Instant access to the full article PDF.
USD 39.95
Prices may be subject to local taxes which are calculated during checkout
Similar content being viewed by others
Author information
Authors and Affiliations
Rights and permissions
About this article
Cite this article
HUSAIN, M. Leaf-Curl in Cotton. Nature 126, 958 (1930). https://doi.org/10.1038/126958b0
Published:
Issue date:
DOI: https://doi.org/10.1038/126958b0